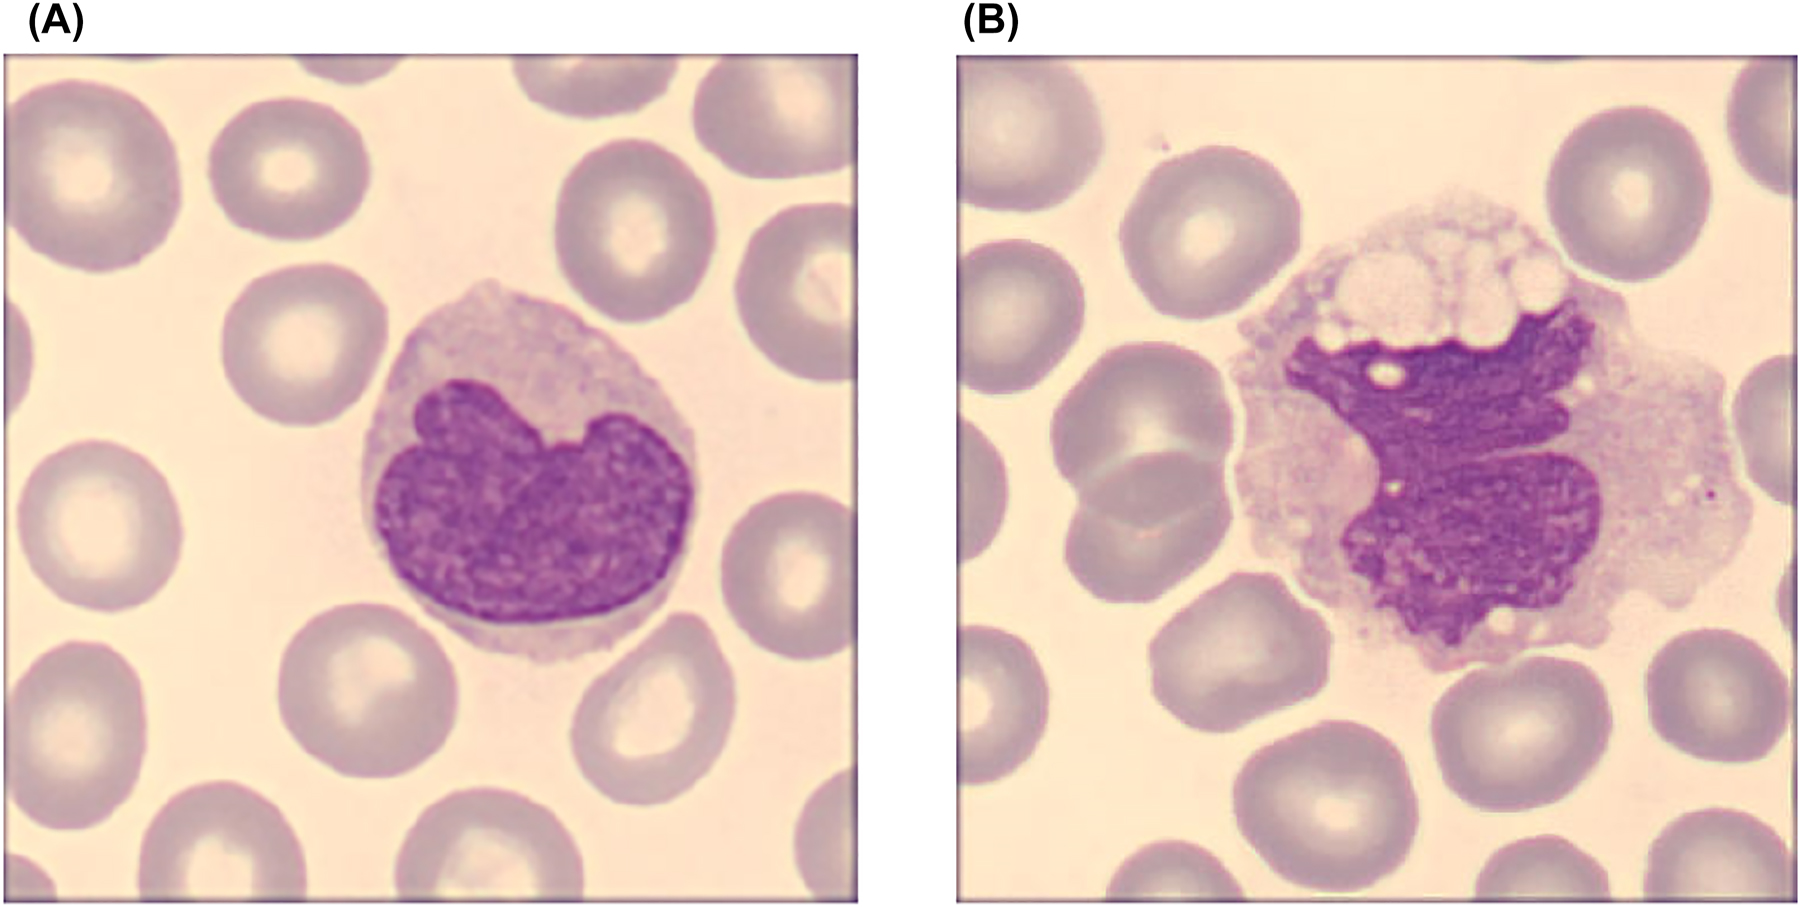
Figure 2: 
Light microscopy images of peripheral blood WBC representative of COVID-19 negative (A) and positive patients (B). Normal monocytes show only occasional and very small cytoplasmic vacuoles, compared to the atypical monocytes with large coalescing cytoplasmic vacuoles typically found in SARS-CoV-2 patients. (May-Grunwald-Giemsa, ×100) (personal unpublished observations).

Abstract
The SARS-CoV-2 infection is characterized by both systemic and organ hyper-thromboinflammation, with a clinical course ranging from mild up-to critical systemic dysfunction and death. In patients with coronavirus disease 2019 (COVID-19) the monocyte/macrophage population is deeply involved as both trigger and target, assuming the value of useful diagnostic/prognostic marker of innate cellular immunity. Several studies correlated morphological and immunophenotypic alterations of circulating monocytes with clinical outcomes in COVID-19 patients, concluding that monocyte distribution width (MDW) may retain clinical value in stratifying the risk of disease worsening. Through an electronic search in Medline and Scopus we performed an updated literature review and meta-analysis aimed to explore the association between increased MDW levels and illness severity in COVID-19 patients, deciphering role(s) and function(s) of monocytes in the harmful network underlining SARS-CoV-2 infection. We found that significantly elevated MDW values were frequently present in COVID-19 patients who developed unfavorable clinical outcomes, compounded by a significant association between monocyte anisocytosis and SARS-CoV-2 outcomes. These findings suggest that blood MDW index and its scatter plot could represent useful routine laboratory tools for early identification of patients at higher risk of unfavorable COVID-19 and for monitoring the progression of viral infection, clinical outcomes, and therapeutic efficacy throughout hospitalization. According to this evidence, therapeutic decisions in patients with SARS-CoV-2 infection could benefit from monitoring MDW value, with administration of drugs limiting thrombo-inflammation due to monocyte hyper-activation in patients with severe/critical COVID-19 disease.
Introduction
Coronavirus disease 2019 (COVID-19) is the worldwide infectious viral disease etio-pathogenetically caused by severe acute respiratory syndrome coronavirus 2 (SARS-CoV-2), which mainly generates respiratory involvement, but may dramatically evolve up-to multi-organ failures (MOF) and death in some cases [1], [2], [3], [4]. A plethora of studies has focused on the clinical manifestations of COVID-19 involving circulating blood cells characteristics and innate immunity, thus revealing a broad complexity of hematology findings in COVID-19. Interestingly, these studies shed light also on the missing pieces of the intricate puzzle of COVID-19, providing information on landscape of involvement of both hematological and immunological cells (reviewed in [5, 6]).
Several studies focused on both morphological alterations and functional modifications of circulating monocytes, suggesting a crucial role and involvement of these important blood cells as both disease trigger and therapeutic target in progressive inflammation during COVID-19 infection [5, 7], [8], [9], [10].
In keeping with prominent and promising laboratory features in both classic and viral sepsis, several recent studies on the diagnostic and prognostic value of routine hemocytometry markers revealed and underlined the clinical usefulness of monocyte distribution width (MDW) in COVID-19 [5, 11], emphasizing the role of this measure for distinguishing and stratifying the risk of developing critical illness and/or dying [12], [13], [14], [15], [16], [17], [18], [19], [20], [21], [22]. To this end, the innovative hematological parameter MDW, linked to heterogeneity of monocyte volume, depends on massive inflammatory activation, and has recently emerged as predictive factor of multiorgan dysfunction and increased risk of death in several physio-pathological conditions [11, 23], [24], [25], [26], [27], [28], [29]. MDW is both a Food and Drug Administration (FDA) and European Community (EC)-approved marker of early sepsis [24, 30], though recent evidence has emerged that its assessment may retain prognostic significance in COVID-19, as novel “viral sepsis” biomarker [13], [14], [15], [16, 18, 20], [21], [22, 31, 32].
According to standard hematological procedures using the exclusive software of the UniCell DxH900 Hematology Analyzer (Beckman Coulter), MDW, which can be generated alongside differential counts of circulating leukocyte populations, is an innovative parameter mathematically based on the measure of specific cell volume index and standard deviation of volume distribution within the monocyte population, according to previously reported details [33, 34]. Noteworthy, MDW measures positional parameters with “VCS technology” (i.e., Volume, Conductivity, and Scatter), by means of three simultaneous and sindependent energy sources: direct current impedance to measure cell volume of all cell types; radio frequency opacity, to characterize conductivity for internal composition of each cell; a laser beam to measure light scatter for cytoplasmic granularity and nuclear structure. These data provide accurate and innovative information on volume, conductivity, and scatter parameters, thus allowing to detect morphologic changes in reactive/activated monocyte cells. This parameter improves and even outperforms the attainment of crucial details through classic optical microscopic evaluation of peripheral blood smears, providing also additional information on heterogeneity and modifications of monocyte volume upon massive inflammatory cascade.
We describe here the results of an updated systematic review and meta-analysis aimed to provide a pooled analysis of studies that have addressed the potential clinical utility of MDW in routine laboratory medicine, exploring the possible association between increased MDW levels, disease severity, and mortality in COVID-19 patients, including a comparison of MDW values between COVID-19 and non-COVID-19 patients.
Search strategies and selection criteria
We carried out an electronic search in Medline (PubMed interface) and Scopus, using the keywords “COVID-19” OR “SARS-CoV-2” AND “monocyte” OR “monocyte distribution width” OR “MDW”, between 2019 and present time (i.e., latest search date: September 19, 2022), restricted to articles published in English. The reference list of all articles was also reviewed for identifying other potentially eligible studies, according to the protocol based on the transparent reporting of systematic reviews and meta-analysis (PRISMA).
The reference list of the documents included in our analysis was also scrutinized with forward and backward citation tracking, to detect other potentially eligible studies. All resulting items were screened (title, abstract and full text, when available or necessary) by three authors (DL, BLS and FM), to capture observational, cross-sectional, or prospective studies reporting data on MDW values at admission (or at the earliest time point during hospitalization) in COVID-19 patients with or without severe disease, as well as in non-survivors vs. survivors. Severe disease was clinically defined as patients needing intensive care unit (ICU) admission, mechanical (forced) ventilation, COVID-19 related hospitalization, pneumonia, or onset of critical symptoms and/or shock and/or presence of organ failure. All studies fulfilling these criteria were then included in a systematic literature review, also providing data for an updated meta-analysis. Disagreements between authors with respect to study eligibility were resolved by discussion and consensus among authors. Results of the review were organized into summary of finding tables. A pooled analysis was then performed, with estimation of weighted mean difference and 95% confidence interval (95% CI) of MDW values in subjects with or without SARS-CoV-2 infection. A random-effect model was used to adjust for potential heterogeneity emerging for the use of different threshold values and sampling time across studies. Heterogeneity was assessed using chi-square test and I 2 statistics. The pooled analyses were performed with MetaXL, software version 5.3 (EpiGear Intl Pty Ltd). The software MetaXL calculates the pooled analyses by using mean, SD, and samples size of populations. For research studies providing median values, and interquartile ranges, the mean and SD have been calculated according to previously published methods [35].
All statistical tests were performed with GraphPad Prism 9.0. Values are expressed as mean ± standard deviations (SD). Unless otherwise specified, significant differences between groups were determined using one-way ANOVA followed by post-hoc test (i.e., Tukey’s multiple comparison test, with a single pooled variance). p values <0.05 were considered significant.
Results
Study identification and characteristics
A total number of 424 studies were initially identified by our search criteria, 222 of which were excluded for duplication among the two databases, whilst 189 were also excluded because they failed to report usable MDW values. Thirteen studies, totaling 5,991 subjects/patients, were finally included in our systematic review and meta-analysis [13, 15], [16], [17], [18], [19], [20, 22, 27, 32, 36], [37], [38]. The Preferred Reporting Items for Systematic Reviews and Meta-Analyses (PRISMA) diagram is shown in Figure 1.

Preferred reporting items for systematic reviews and meta-analyses (PRISMA) diagram.
The selected studies were characterized as observational studies, prospective observational studies, or cross-sectional consecutive studies. All COVID-19 patients were hospitalized, and the diagnosis was confirmed by FDA-approved RNA testing (i.e., RT-PCR assays using nasopharyngeal swab, pharyngeal swab, bronchoalveolar lavage), and clinically confirmed by chest X-ray and/or CT-scan, according to guidelines and severity classification of the World Health Organization (WHO). Several studies also included non-COVID hospitalized patients, but all patients were compared to healthy, or COVID-19 negative control subjects analyzed in a routine diagnostic setting.
All MDW measurements were conducted using the UniCell DxH900 or with UniCell DxH800 [22, 32] hematology analyzers, on whole blood venous samples collected on K2EDTA (where specified) and analyzed according to routine methods for cell blood count and determination of positional parameters, including MDW. All reported blood MDW values were measured upon hospital admission or at the earliest time point immediately after hospitalization. The present overview was exempted from Ethical Committee approval as not locally required for meta-analyses and did not receive any funding.
Narratively, among the plethora of studies focused on morphological anomalies of circulating blood cells in COVID-19 patients, some investigations using optical and electron microscopy and flow cytometry approaches clearly demonstrated that striking numeric and morphological white blood cell changes could be observed in COVID-19 patients. These reports highlighted pronounced multi-lineage aberrations in monocytes, mainly due to abnormal vacuolization and coalescing vacuoles, which were significantly associated with disease severity progression but were progressively lost upon remission [39], [40], [41], [42].
A dysregulated host innate immune response, mainly due to altered balance of monocyte/macrophage activation amplified by specific cytokine pattern, is well known and established process during COVID-19(43). In particular, the presence in all phases of SARS-CoV-2 infection of both monocyte and macrophage populations (main players in the innate immunity, triggering systemic inflammation, pro-coagulant syndrome, and cytokine release syndrome) can act as a double-edged sword, ameliorating or exacerbating the viral infection, fostering multiorgan failure (MOF) and influencing severity and outcome of SARS-CoV-2 infection [5]. Accordingly, it has been widely demonstrated that increased levels of inflammatory monocytes (i.e., CD14+ CD16+ IL-6+ GM-CSF+ monocytes) lead to deleterious clinical manifestations and even acute mortality in COVID-19 infection through a pathogenic mechanism involving Th1 lymphocytes and inflammatory monocytes expressing IL-6 [9]. Notably, biomolecular pathways contributing to hyperactivation of monocyte-derived macrophages and hyperinflammation-hypercoagulation in COVID-19 have been described [5, 8].
All these studies paved the way for accurate analysis of volume, cytoplasmic inclusions, surface molecules-cluster of differentiation, and inflammation-related phenotypic changes of monocytes, early suggesting that MDW may be a possible additional biomarker for predicting disease severity and clinical course of COVID-19 infection [6, 7, 12].
The innovative role of MDW seems mostly linked to the heterogeneity of monocyte volume and inherently associated with a massive inflammatory reaction, thus becoming an attractive biomarker for predicting multiorgan dysfunction and increased mortality rate in several physio-pathological conditions, including Sepsis [11, 24, 30] and COVID-19 infections [14, 18].
According to the PRISMA diagram (Figure 1), a total of thirteen articles were selected for our pooled analyses, totaling 5,991 subjects, 4,131 of whom were patients with SARS-CoV-2 infection (68.9%) [13, 15], [16], [17], [18], [19], [20, 22, 27, 32, 36], [37], [38].
For better evaluation and comprehension of data complexity in the interplay between MDW and COVID-19, and to provide updated/improved meta-analysis, we divided the selected studies based on reported MDW values in patients with and without SARS-CoV-2 infection (n=5) [16, 17, 22, 27, 38] and MDW levels measured only in patients with COVID-19, without direct comparison with healthy or COVID-19 negative control subjects (n=8) [13, 15, 18], [19], [20, 32, 36, 37]. Finally, we also analyzed studies comparing MDW values between mild and severe clinical conditions or survivors vs. non-survivors (n=7) [13, 15, 16, 19, 20, 36, 37]. In these studies, the cut-off was set at a similar threshold, ranging from ≥20 [16] to ≥21 [19], even if some studies proposed a stratifying COVID-19 working model with “low, intermediate and high MDW values” (<20, 20–26.4 and >26.4, respectively) [14], and other described values >22 or >24 as strongly associated with unfavorable outcome in COVID-19 (i.e., non-survivor patients) [18, 32].
MDW index between patients with and without SARS-CoV-2 infection and monocyte morphology
As summarized in Table 1, MDW values in COVID-19 positive patients were always higher than those in control subjects (i.e., COVID-19 negative), demonstrating that the circulating monocyte population had a significantly changed heterogeneity of monocyte volume, conductivity, and scatter parameters in patients with SARS-CoV-2 infection.
MDW values in patients with and without SARS-CoV-2 infection.
| Authors | Controlsa, n | COVID-19, n | MDW values (mean ± SD) COVID-19 (−) vs. COVID-19 (+) | p-Value |
|---|---|---|---|---|
| Ognibene et al. [16] | 106 | 41 | 20.3 ± 3.3 vs. 27.3 ± 4.9 | <0.005 |
| Lin et al. [17] | 141 | 9 | 21.8 ± 5.4 vs. 23.5 ± 2.1 | 0.096 |
| Zeng et al. [22] | 62 | 93 | 18.9 ± 2.0 vs. 22.1 ± 2.3 | <0.0001 |
| Piva et al. [27] | 1,540 | 243 | 22.1 ± 3.3 vs. 26.2 ± 4.3 | <0.001 |
| Cusinato et al. [38] | 11 | 15 | 16.0 ± 1.2 vs. 23.0 ± 4.3 | <0.001 |
The significantly increased values of MDW observed in COVID-19 patients by a routine hematological analyzer are directly correlated to the morphological changes observed by light microscopy in monocyte cells through May-Grunwald-Giemsa-stained blood smears, as depicted in Figure 2.
Light microscopy images of peripheral blood WBC representative of COVID-19 negative (A) and positive patients (B). Normal monocytes show only occasional and very small cytoplasmic vacuoles, compared to the atypical monocytes with large coalescing cytoplasmic vacuoles typically found in SARS-CoV-2 patients. (May-Grunwald-Giemsa, ×100) (personal unpublished observations).
The morphological alterations of circulating monocytes observed by light microscopy in COVID-19 patients were also confirmed in studies performed through electron microscopy, demonstrating ultrastructural equivalent changes, larger monocytes, aberrant nuclei with clumped chromatin, prominent and diffuse coalescing vacuolization, which displayed a more atypical profile correlated with the disease outcome (e.g., ICU and non-survivors patients) [39], [40], [41], [42]. Interestingly, despite monocytes/macrophages play a significant role in sustaining a hyperinflammatory response in SARS-CoV-2 infection [8, 9, 43], literature data suggested that not all COVID-19 patients display significant monocyte morphological changes [44]. These discrepancies may be explained by either the presence of different monocyte subsets with different functional characteristics in mild and severe disease states (e.g., higher percentage of nonclassical CD14+ CD16+ inflammatory monocytes enriched in peripheral blood of more severe COVID-19 patients) [9, 38, 42], or different amounts of peculiar monocyte inflammatory triggers in patients with severe COVID-19 disease (e.g., proinflammatory cytokines, histones, etc.) [45, 46].
Although the data characterizing the innate immune system and inflammatory/thrombotic status in patients with COVID-19 are emerging and in itinere, it is clear that hyperinflammation (the so called “cytokine storm”), coagulopathy and monocyte/macrophage represent an intricate network of pathways converging to foster disease severity and increasing the risk of death in patients with SARS-CoV-2 infection. A better understanding of laboratory biomarkers (including MDW) which may be helpful for improving risk stratification in COVID-19 patients (especially the risk of developing hyperinflammation/hypercoagulation) appears crucial for identifying and better characterizing the biomolecular basis of this disease, as well as for developing rationale-based clinical therapeutic strategies.
MDW values in SARS-CoV-2 positive patients with non-severe and severe illness/death
The analysis of literature data about MDW values in COVID-19 patients is summarized in Table 2, highlighting the difference in terms of clinical severity (mild vs. severe, 343 vs. 311, or survivors vs. non-survivors, 103 vs. 24, respectively).
MDW values in COVID-19 patients with and without severe illness or mortality.
| Authors | Study | COVID-19 positive (n; mean ± SD) | p-Value | |
|---|---|---|---|---|
| Mild vs. severe | Survivors vs. non-survivors | |||
| Ognibene et al. [16] | Observational, prospective, single-center | n: 18 vs. 23 25.4 ± 3.6 vs. 28.8 ± 5.3 |
<0.005 | |
| Riva et al. [13] | Retrospective, observational, single-center | n: 71 vs. 16 20.5 ± 4.0 vs. 26.8 ± 4.8 |
<0.001 | |
| Stratan et al. [36] | Retrospective, single-center | n: 41 vs. 65 20.7 ± 2.9 vs. 24.5 ± 3.4 |
<0.05 | |
| Lorubbio et al. [15] | Retrospective, single-center | n: 32 vs. 8 26.2 ± 3.4 vs. 24.8 ± 3.0 |
<0.005 | |
| Lin et al. [19] | Retrospective, single-center | n: 72 vs. 48 23.5 ± 4.4 vs. 25.2 ± 4.6 |
0.0177 | |
| Hossain et al. [20] | Retrospective, single-center | n: 156 vs. 162 23.3 ± 3.7 vs. 25.7 ± 3.7 |
<0.0001 | |
| Kim et al. [37] | Retrospective, single-center | n: 56 vs. 13 21.6 ± 3.1 vs. 25.8 ± 3.9 |
<0.001 | |
-
Of note, the data included from Kim et al. [37] are referred to patients with mechanical ventilation or high-flow nasal cannula oxygen therapy for the severe group and no oxygen therapy for the mild group, due to the absence of further details to classify the disease severity; the data included from Lin et al. [19] are referred to patients with a length of stay >14 days for the severe group and a LOS ≤14 days for the mild group, due to the absence of MDW details according to the disease severity as categorized into mild, moderate, severe and critical.
A high significant difference was found in all studies in terms of clinical severity, thus suggesting a possible association between monocyte anisocytosis and biomolecular inflammatory activation, especially in those patients with metabolic, inflammatory, proteolytic, and thrombotic processes capable to trigger severe multiorgan pathologies and death [13, 15, 16, 19, 20, 36, 37].
In particular, Riva et al. [13] and Lorubbio et al. [15] classified COVID-19 patients according to the disease outcome, in survivors and non survivors; however, Riva et al. did not provide other information on the disease class in each group, whereas, Lorubbio et al. collected data from severe COVID-19 patients hospitalized for >4 days, and detailed that the 8 non survivors required high-flow nasal cannula O2 therapy, and among the survivors 22 required no-invasive ventilation O2 therapy, and 10 required high-flow nasal cannula O2 therapy.
On the other hand, Stratan et al. [36] classified COVID-19 patients in moderate-severe disease (severe group) vs. mild disease/no pulmonary lesions (mild group); Ognibene et al. [16] classified COVID-19 patients in few symptomatic (mild group) and patients requiring hospitalization in high-intensity care unit (severe group); Kim et al. [37] referred to patients needing for mechanical ventilation or high-flow nasal cannula oxygen therapy (severe group) vs. patients no needing for oxygen therapy (mild group); Hossain et al. [20] referred to patients with or without respiratory failure (severe and mild group, respectively); Lin et al. [19] classified COVID-19 positive patients according to the length of stay >14 days (severe group) and a LOS ≤14 days (mild group).
Although the studies did not report clear indications on diagnostic cut-offs, the weighted mean value of MDW in COVID-19 patients with mild condition was 22.9 ± 3.6 (n=343), significantly lower than that in patients with severe COVID-19 (25.6 ± 3.9, n=311). The paucity of data describing MDW levels between survivors and non-survivors did not allow to make definitive conclusions, even with strong indication for a significant difference between the weighted mean MDW levels in survivors vs. non-survivors COVID-19 patients (22.3 ± 3.8 vs. 26.1 ± 4.2, n=127). Up-to now, only a recent study described graphical data on monocyte heterogeneity [47] and only a few reports provided images of altered/atypical monocytes circulating in blood in these COVID-19 patients [39], [40], [41]. Moreover, some studies described a significant relationship between MDW and inflammatory biomarkers (like C-reactive protein, ferritin, etc.) [13, 17, 19, 36, 37], but only few performed a comprehensive analysis of correlation among MDW and other laboratory biomarkers (full blood cell count, inflammation and coagulation biomarkers, and serum enzymes) [18, 36].
Actually, no data are available on possible MDW differences due to sex or age in COVID-19 patients, thus highlighting the need of designing additional studies aimed at evaluating if monocyte and MDW could be a novel part of gender medicine (e.g., sex-dependent number or histone sensitivity) or whether patient’s age (e.g., young or old monocytes) may justify/explain the different sensitivity to biomolecular triggers (e.g., as in COVID-19 viral sepsis and classical bacterial/fungal sepsis). Nonetheless, all these data support and emphasize the importance of MDW not only as additional routine hematological parameter and innovative prognostic biomarker in COVID-19, but also as promising test for monitoring clinical progression in patients with viral sepsis.
Meta-analyses of MDW values in COVID-19 patients
Among the 13 articles initially detected with our search criteria, 8 ought to be excluded because they did not provide usable MDW values in patients with and without COVID-19. A total of five studies, with 2.261 subjects (401 with COVID-19, 17.7%, range 2.2–60.6%) were finally included in our pooled analysis [16, 17, 22, 27, 38] (Table 3).
Main characteristics of the studies included in the pooled analysis of patients with and without COVID-19.
| Authors | Setting | Sample size | MDW cut-off | COVID-19 infection | MDW values (without vs. with SARS-CoV-2 infection) | p-Value |
|---|---|---|---|---|---|---|
| Lin et al. [17] | Taiwan | 150 | ≥20 | 9 (6%) | 21.8 ± 5.4 vs. 23.5 ± 2.1 | 0.096 |
| Ognibene et al. [16] | Italy | 147 | ≥20 | 41 (27.9%) | 20.3 ± 3.3 vs. 27.3 ± 4.9 | <0.005 |
| Piva et al. [27] | Italy | 1.783 | ≥20.1 | 243 (13.6%) | 22.0 ± 3.3 vs. 26.0 ± 4.3 | <0.001 |
| Zeng et al. [22] | China | 155 | ≥20.1 | 93 (60.0%) | 18.9 ± 2.0 vs. 22.1 ± 2.3 | <0.0001 |
| Cusinato et al. [38] | UK | 26 | ≥20 | 15 (57.7%) | 16.0 ± 1.2 vs. 23.0 ± 4.3 | <0.001 |
| Cumulative | 2.261 | 401 (17.7%) | 21.8 ± 3.4 vs. 25.2 ± 3.9 | <0.0001 |
-
Bold values indicate the cumulative statistical data respect to the single studies reported.
These studies underlined wide heterogeneity of subject characteristics, since they were comparing COVID-19 vs. upper respiratory tract infection [17], pauci-symptomatic vs. symptomatic patients [16], COVID-19 vs. sepsis and no-sepsis [27], and negative vs. positive COVID-19 patients [22].
Besides, COVID-19 patients were differently classified in each study. In particular, Ognibene et al. [16] classified patients in high-intensity care unit hospitalized vs. few symptomatic patients; Piva et al. [27] classified patients according to the presence or absence of sepsis of different origin (including SARS-CoV-2 infection), presenting to the ICU, and hospitalized for at least 24 h; Zeng et al. [22] collected data from COVID-19 hospitalized patients, with fever, dry cough, shortness of breath, fatigue, myalgias, and diarrhea as main symptoms; Cusinato et al. [38] recruited adult patients admitted to the emergency department with SARS-CoV-2 infection and healthy volunteers as controls; Lin et al. [17], enrolled consecutive patients admitted to the ED with fever, respiratory symptoms, or travel history and with suspected COVID-19.
Although in all five studies the cut-off was similar, our updated analysis revealed that MDW values were significantly higher in patients with COVID-19, confirming and improving a previous similar analysis [21]. As reported in the updated forest plot, we found consistent heterogeneity (as demonstrated by Higgins heterogeneity index I 2=88) with a Q Cochran test of 32.05; the analysis revealed also that MDW was 15.6% higher in COVID-19 patients than in those without infection (WMD 4.42, 95% CI, 3.05–5.78) (Figure 3).

Forest plot of weighted mean difference and 95% confidence interval of MDW values in negative vs. positive COVID-19 patients.
Although the total number of papers available so far was low and lacked uniformity, we still performed a new pooled analysis of MDW in the subgroups of COVID-19 patients, comparing mild plus survivors vs. severe/critical plus non-survivors conditions; a total of 7 studies provided detailed information, with 781 COVID-19 patients, 446 with mild + survivors profile and 335 with severe/critical (n=311) + non-survivors conditions (n=24) (92.8 vs. 7.2%, respectively) [13, 15, 16, 19, 36, 37] (Table 4).
Main characteristics of the studies included in the pooled analysis of patients with mild and severe COVID-19 conditions.
| Authors | Setting | Sample size | Severe/critical + non-survivors COVID-19 | Mild + survivors COVID-19 | MDW values (mild + survivors vs. severe/critical + non-survivors) |
|---|---|---|---|---|---|
| Ognibene et al. [16] | Italy | 41 | 23 (56.1%) | 18 (43.9%) | 25.4 ± 3.6 vs. 28.8 ± 5.3 |
| Riva et al. [13] | Italy | 87 | 16 (18.4%) | 71 (81.6%) | 20.5 ± 4.0 vs. 26.8 ± 4.8 |
| Stratan et al. [36] | Romania | 106 | 65 (61.3%) | 41 (38.7%) | 20.7 ± 2.9 vs. 24.5 ± 3.4 |
| Lorubbio et al. [15] | Italy | 40 | 8 (20%) | 32 (80%) | 26.2 ± 3.4 vs. 24.8 ± 3.0 |
| Lin et al. [19] | Taiwan | 120 | 48 (40%) | 72 (60%) | 23.5 ± 4.4 vs. 25.2 ± 4.6 |
| Hossain et al. [20] | USA | 318 | 162 (50.9%) | 156 (49.1%) | 23.3 ± 3.7 vs. 25.7 ± 3.7 |
| Kim et al. [37] | Korea | 69 | 13 (18.8%) | 56 (81.2%) | 21.6 ± 3.1 vs. 25.8 ± 3.9 |
| Cumulative | 781 | 335 (42.9%) | 446 (57.1%) | 22.7 ± 3.7 vs. 25.6 ± 3.9 |
-
Bold values indicate the cumulative statistical data respect to the single studies reported.
In all seven studies MDW values were higher in patients with severe/critical SARS-CoV-2 infection than in those with mild infection, as shown in Table 4. Despite relevant heterogeneity (as demonstrated by Higgins index of I 2=77, and a Q Cochran test of 25.99), and although the weighted MDW values displayed wide variability (ranging from −1.4 to 6.3), MDW in severe COVID-19 was 12.8% higher than in patients with mild infection (overall WMD 2.87, 95% CI, 1.53–4.20) (Figure 4).

Forest plot of weighted mean difference and 95% confidence interval of MDW values in positive COVID-19 patients with mild + survivor and severe/critical + non-survivor conditions.
We also performed a comparison of MDW values among the subgroups of COVID-19 positive patients, categorized as mild + survivors and severe/critical + nonsurvivors. As shown in Figure 5, we highlighted a significantly different MDW value between controls and patients with mild + survivor condition (p=0.01–0.05), as well as between mild + survivor vs. severe/critical + non-survivor COVID-19 patients (p=0.01–0.05); this difference became highly significant when comparing healthy control vs. severe/critical + non-survivor COVID-19 patients (p=0.0001–0.001).

MDW values in positive COVID-19 patients with mild + survivor and severe/critical + non-survivor conditions (*: p=0.01–0.05; **: p=0.001–0.01; ***: p=0.0001–0.001).
Discussion
The scientific community has provided tremendous efforts against the harmful pandemic of SARS-CoV-2, focusing on identification of pathogenic biomolecular pathways and laboratory biomarkers with possible diagnostic and prognostic applications, in order triggers and targets for therapeutic approaches [2, 48, 49]. Among the various laboratory findings observed in COVID-19 [12, 48, 50, 51], several studies focused on extracellular traps of both neutrophils and monocytes (ETs) [52], [53], [54], which have now emerged as diagnostic and prognostic biomarkers COVID-19, since they are actively involved in both cytokine storm and coagulation dysfunctions [55], [56], [57].
As recently overviewed by Ligi et al. [58], extracellular histones (released as unmodified and/or citrullinated proteins from inflammatory activated leukocytes, in particular circulating monocytes) have gained momentum due to their well-known role in fostering organ injuries and systemic diseases [59, 60], thus emerging as reliable diagnostic and/or prognostic markers of ETosis in SARS-CoV-2 infection [3, 52, 53, 61], due to their active role in COVID-19 related immunothrombosis and thromboinflammation [56] which are main causes of severe illness [45, 62]. Interestingly, early identification in COVID-19 of hyperhistonemia, which has been associated with higher mortality risk [46, 63], will predictably provide novel unexpected insights on whether circulating histone monitoring may be helpful in patients with SARS-CoV-2 infection [45].
We have recently shown that histone treatment of healthy whole blood produces a significant alteration of both monocyte morphology and MDW [47], demonstrating that histone play a crucial role in triggering profound and harmful, time- and dose-dependent modifications of circulating monocytes, likely those found in bacterial/fungal and viral (thus including SARS-CoV-2) sepsis.
The results of our systematic literature review demonstrate that COVID-19 patients have significantly higher MDW levels compared to healthy control subjects, and that patients with SARS-CoV-2 infection developing worse outcomes have higher MDW values than those with better outcomes. However, careful analysis of the included studies reveals a more complex and variable biochemical picture, due to the variability of the study population.
Although the SARS-CoV-2 pandemic is still ongoing and there is an impressive involvement of the scientific community to investigate from a biological, biochemical, molecular, and clinical perspective the different aspect of this life-threatening disease, the number of studies available so far on the innovative topic of MDW remains limited; the main limitation is mostly due to lack of uniformity about a cut-off for general population and subgroups of COVID-19 patients, other than an evident heterogeneity of leukocyte response (e.g., monocyte, neutrophil and lymphocyte) to the triggers of this infection.
Irrespective of these shortcomings, this systematic review and updated pooled analyses strongly suggest that MDW values may be higher in subjects with active SARS-CoV-2 infection than in those without, and that MDW may be a promising biomarker for distinguishing COVID-19 patients at major risk of unfavorable disease progression. Actually, no data are available on pharmacological agents that may be effective to down-regulate MDW values in COVID-19 patients, as well as therapeutic approaches restoring or at least improving monocyte functions and natural immunity, or even reverting the well-documented alterations of monocyte morphology and their harmful inflammatory activation that may frequently increase the risk of MOF and/or death.
Despite the technology beyond MDW assessment is unique, heterogeneous variability of patients’ clinical data has emerged, though a substantial concordance has been reached that MDW plays an important role as additional diagnostic biomarker for predicting the risk of developing severe disease and/or death.
Notably, circulating monocytes were often found in normal values despite the clear heterogeneity of this leukocyte population (i.e., monocyte anisocytosis), as highlighted by the MDW scatter plots. Noteworthy, MDW was found to be low in most control subjects (under the proposed cut-off of 20–21) and not significantly higher in mild/survivor COVID-19 patients. Patients who developed severe/critical COVID-19 illness and unfavourable clinical outcomes were identified and stratified as having higher risk of mortality based on MDW values [13, 15, 16, 19, 20, 36, 37] (Figure 5).
As reported by Lin et al. [17] and Kim et al. [37], MDW values were not significantly elevated in patients with COVID-19, even compared with those with upper respiratory tract infections and in patients with mechanical ventilation, according to the main cytopathic effects of SARS-CoV-2 infection on lung cells [64]. Interestingly, Polilli et al. [32], through a predictive models carried out on a retrospective study of 536 COVID-19 patients, showed that MDW values >22 and >25 was strongly predicted hospitalization and ICU admission. According to the well-known monocytes/macrophages involvement in immunopathogenesis of both systemic and organ (e.g., lung) hyperinflammatory manifestations (especially in COVID-19 infection), MDW values and scatter plots (alongside differential counts of circulating leukocytes) represent innovative routine and promising biomarker to reveal monocyte anisocytosis and their inflammatory activation and altered biomolecular functions. These crucial monocyte conditions and behaviors are in agreement with literature data about morphological, biochemical, cytometric and molecular modifications of monocytes in patients with COVID-19 [5, 8], [9], [10], [11, 40, 41]. In particular, the role of circulating monocytes as well as their activation and different expansion of subsets (e.g., from classical to nonclassical and intermediate monocyte populations) has been widely discussed as primary innate immunity cells involved in SARS-CoV-2 disease severity and death correlated to the immune, inflammatory and thrombotic status of these patients [8, 9, 43, 65].
To this end, morpho-functional alterations of monocytes during COVID-19 have been not only related to dysregulated innate immunity and hyperinflammatory syndrome (mainly due to cytokine storm), but also to crucial release and activation in blood milieu and tissues of procoagulant triggers and pathways (e.g., tissue factor, platelet interaction inducing factor V and XIII release, D-dimer, etc.), thus linking hyperinflammation of monocytes to hypercoagulability clinical profile [6, 12, 36, 48, 66].
The hyperactivation of monocytes in COVID-19 patients also represents a further trigger to induce platelet activation, thus promoting coagulation dysfunctions. In fact, monocytes from patients with severe COVID-19 have been characterized to be more predisposed to bind platelets [67]. Platelets, as well, reciprocally activate monocytes in SARS-CoV-2 infection, promoting tissue factor (TF) expression and inflammatory cytokine release, exacerbating the vicious cycle of thrombo-inflammation [68].
Although the evidence on morpho-functional alterations of monocytes and significantly increased MDW levels reinforce the multifactorial pathogenesis of severe COVID-19 illness, on the other hand provides novel evidence on the significant role of monocytes and MDW scatters in SARS-CoV-2 viral sepsis, especially in COVID-19 patients with unfavorable clinical progression, paving the way for future perspectives of these hematological biomarkers in diagnostic algorithms [11, 32].
Noteworthy, there is still limited information about MDW evaluation in young COVID-19 patients, although some of them may be at risk of developing life-threatening complications and/or the multisystem inflammatory syndrome in children (MIS-C) [11, 69, 70]. Although children are often only mildly symptomatic or asymptomatic during acute SARS-CoV-2 infection, the emergence of novel SARS-CoV-2 lineages, the waning mRNA vaccine and natural immunity and vaccine hesitancy may have a serious impact on the number of young cases with severe illness [71, 72]. A stepwise approach for laboratory workup for diagnosing MIS-C has been advocated [69], though only recently MDW was found to be an additional hematological parameter reflecting monocyte anisocytosis [70].
Conclusions and future perspectives
The involvement and crucial functions of monocyte and its related marker MDW, and their impact on COVID-19 requires new strategies to address these changes in clinics and laboratory medicine. SARS-CoV-2 infection triggers significant organic injuries, especially mediated by thrombo-inflammation [73], which may lead patients to a higher risk of severe/critical conditions (up-to death) in the short term, whilst also fostering “chronic” complications and health consequences in the medium-long term due to accumulation of viral triggers [74]. Although the dynamics of these processes seem related to unresolved hyperinflammation of circulating monocytes [75], it will need further scrutiny for clarifying under which biological circumstances (e.g., clinical features, epigenetic and biomolecular hallmarks) accelerate or evolve toward multi-organ failure [3], and whether it may be partially or completely reversible [76].
The organic injury following SARS-CoV-2 infection has multifactorial causes, so that a combination of both “old and new” biomarkers [48, 50, 77, 78] may be more suited for risk prediction. The results of our systematic literature review and updated meta-analysis suggest that monitoring MDW and morphological monocyte anisocytosis in patients with SARS-CoV-2 infection (upon admission and throughout hospitalization, especially in critical patients and/or those needing intensive care) may be seen as a useful tool for early identification of patients at higher risk of unfavorable disease evolution and predicting viral progression and complications. Moreover, according to recent observations on possible therapeutic approaches protecting cells and tissues (e.g., endothelial, pulmonary and cardiac cells) from inflammatory and thrombotic insults [45, 49, 79], [80], [81], future studies will be needed to identify both direct and indirect effects on cell activation and cytopathies of SARS-CoV-2 infection. A predictive/mechanistic scheme of how circulating COVID-19 virus may interplay with the innate immune response of circulating monocytes and trigger both inflammatory process and coagulative cascade mediated by monocyte alterations (mirrored by MDW index alterations) is summarily depicted in Figure 6.

The key roles and functions of monocytes/macrophages and MDW index in the pathological inflammation in patients with mild and severe infection.
Finally, further studies should be planned to define the role of MDW within diagnostic algorithms, and focused, in our opinions, to these main topics:
On the basis of recent literature evidence suggesting different monocyte responses to COVID-19 and MIS-C according to the age of patients and monocyte subpopulations [82], [83], [84], it will be important to establish both ageing cohorts of COVID-patients and well-matched controls, identifying potential differences in monocyte response associated with ageing(pre-term, neonatal, infant/adolescent, adult, and aged subjects/patients) [85, 86].
Optimization of biological features of circulating biomarkers (e.g., subpopulations of monocytes; link between MDW and other laboratory biomarkers) for being used in routine clinical practice and for opening new frontiers in monitoring disease progression in those receiving pharmacological targeted therapies (e.g., heparin and heparinoids) [45, 49, 79], [80], [81, 88].
In conclusion, this systematic review and updated meta-analysis highlighted the MDW index (a parameter mirroring the changes in monocytes volume and heterogeneity in response to pro-inflammatory signals from COVID-19) as an additional, useful, innovative, and promising parameter for risk stratification that may serve, jointly with monocyte evaluation of morpho-functional alterations within a panel of hematologic/biochemical/immune biomarkers [48, 50, 77, 78], as reliable clinical predictor in COVID-19.
-
Research funding: None declared.
-
Author contributions: All authors have accepted responsibility for the entire content of this manuscript and approved its submission.
-
Competing interests: Authors state no conflict of interest.
-
Informed consent: Not applicable.
-
Ethical approval: Not applicable.
References
1. Mokhtari, T, Hassani, F, Ghaffari, N, Ebrahimi, B, Yarahmadi, A, Hassanzadeh, G. COVID-19 and multiorgan failure: a narrative review on potential mechanisms. J Mol Histol 2020;51:613–28. https://doi.org/10.1007/s10735-020-09915-3.Search in Google Scholar PubMed PubMed Central
2. Lotfi, M, Hamblin, MR, Rezaei, N. COVID-19: transmission, prevention, and potential therapeutic opportunities. Clin Chim Acta 2020;508:254–66. https://doi.org/10.1016/j.cca.2020.05.044.Search in Google Scholar PubMed PubMed Central
3. Kgatle, MM, Lawal, IO, Mashabela, G, Boshomane, TMG, Koatale, PC, Mahasha, PW, et al.. COVID-19 is a multi-organ aggressor: epigenetic and clinical marks. Front Immunol 2021;12:752380. https://doi.org/10.3389/fimmu.2021.752380.Search in Google Scholar PubMed PubMed Central
4. Lippi, G, Mattiuzzi, C, Henry, BM. Updated picture of SARS-CoV-2 variants and mutations. Diagnosis (Berl) 2021;9:11–7. https://doi.org/10.1515/dx-2021-0149.Search in Google Scholar PubMed
5. Ahmadi, E, Bagherpour, Z, Zarei, E, Omidkhoda, A. Pathological effects of SARS-CoV-2 on hematological and immunological cells: alterations in count, morphology, and function. Pathol Res Pract 2022;231:153782. https://doi.org/10.1016/j.prp.2022.153782.Search in Google Scholar PubMed PubMed Central
6. Shahri, MK, Niazkar, HR, Rad, F. COVID-19 and hematology findings based on the current evidences: a puzzle with many missing pieces. Int J Lab Hematol 2021;43:160–8. https://doi.org/10.1111/ijlh.13412.Search in Google Scholar PubMed PubMed Central
7. Khartabil, TA, Russcher, H, van der Ven, A, de Rijke, YB. A summary of the diagnostic and prognostic value of hemocytometry markers in COVID-19 patients. Crit Rev Clin Lab Sci 2020;57:415–31. https://doi.org/10.1080/10408363.2020.1774736.Search in Google Scholar PubMed
8. Merad, M, Martin, JC. Pathological inflammation in patients with COVID-19: a key role for monocytes and macrophages. Nat Rev Immunol 2020;20:355–62. https://doi.org/10.1038/s41577-020-0331-4.Search in Google Scholar PubMed PubMed Central
9. Zhou, Y, Fu, B, Zheng, X, Wang, D, Zhao, C, Qi, Y, et al.. Pathogenic T-cells and inflammatory monocytes incite inflammatory storms in severe COVID-19 patients. Natl Sci Rev 2020;7:998–1002. https://doi.org/10.1093/nsr/nwaa041.Search in Google Scholar PubMed PubMed Central
10. Zini, G, Bellesi, S, Ramundo, F, d’Onofrio, G. Morphological anomalies of circulating blood cells in COVID-19. Am J Hematol 2020;95:870–2. https://doi.org/10.1002/ajh.25824.Search in Google Scholar PubMed PubMed Central
11. Wu, J, Li, L, Luo, J. Diagnostic and prognostic value of monocyte distribution width in sepsis. J Inflamm Res 2022;15:4107–17. https://doi.org/10.2147/jir.s372666.Search in Google Scholar PubMed PubMed Central
12. Lippi, G, Plebani, M. The critical role of laboratory medicine during coronavirus disease 2019 (COVID-19) and other viral outbreaks. Clin Chem Lab Med 2020;58:1063–9. https://doi.org/10.1515/cclm-2020-0240.Search in Google Scholar PubMed
13. Riva, G, Castellano, S, Nasillo, V, Ottomano, AM, Bergonzini, G, Paolini, A, et al.. Monocyte distribution Width (MDW) as novel inflammatory marker with prognostic significance in COVID-19 patients. Sci Rep 2021;11:12716. https://doi.org/10.1038/s41598-021-92236-6.Search in Google Scholar PubMed PubMed Central
14. Riva, G, Nasillo, V, Luppi, M, Tagliafico, E, Trenti, T. Linking COVID-19, monocyte activation and sepsis: MDW, a novel biomarker from cytometry. EBioMedicine 2022;75:103754. https://doi.org/10.1016/j.ebiom.2021.103754.Search in Google Scholar PubMed PubMed Central
15. Lorubbio, M, Tacconi, D, Iannelli, G, Feri, M, Scala, R, Montemerani, S, et al.. The role of monocyte distribution width (MDW) in the prognosis and monitoring of COVID-19 patients. Clin Biochem 2022;103:29–31. https://doi.org/10.1016/j.clinbiochem.2022.02.007.Search in Google Scholar PubMed PubMed Central
16. Ognibene, A, Lorubbio, M, Magliocca, P, Tripodo, E, Vaggelli, G, Iannelli, G, et al.. Elevated monocyte distribution width in COVID-19 patients: the contribution of the novel sepsis indicator. Clin Chim Acta 2020;509:22–4. https://doi.org/10.1016/j.cca.2020.06.002.Search in Google Scholar PubMed PubMed Central
17. Lin, HA, Lin, SF, Chang, HW, Lee, YJ, Chen, RJ, Hou, SK. Clinical impact of monocyte distribution width and neutrophil-to-lymphocyte ratio for distinguishing COVID-19 and influenza from other upper respiratory tract infections: a pilot study. PLoS One 2020;15:e0241262. https://doi.org/10.1371/journal.pone.0241262.Search in Google Scholar PubMed PubMed Central
18. Alsuwaidi, L, Al Heialy, S, Shaikh, N, Al Najjar, F, Seliem, R, Han, A, et al.. Monocyte distribution width as a novel sepsis indicator in COVID-19 patients. BMC Infect Dis 2022;22:27. https://doi.org/10.1186/s12879-021-07016-4.Search in Google Scholar PubMed PubMed Central
19. Lin, SF, Lin, HA, Chuang, HC, Tsai, HW, Kuo, N, Chen, SC, et al.. Fever, tachypnea, and monocyte distribution width predicts length of stay for patients with COVID-19: a pioneer study. J Personalized Med 2022;12:449. https://doi.org/10.3390/jpm12030449.Search in Google Scholar PubMed PubMed Central
20. Hossain, R, Ayub, S, Tarabichi, Y. Monocyte distribution width adds prognostic value in detection of COVID-19 respiratory failure. Int J Lab Hematol 2022;44:e64–6. https://doi.org/10.1111/ijlh.13712.Search in Google Scholar PubMed PubMed Central
21. Lippi, G, Sanchis-Gomar, F, Henry, BM. Pooled analysis of monocyte distribution width in subjects with SARS-CoV-2 infection. Int J Lab Hematol 2021;43:O161–3. https://doi.org/10.1111/ijlh.13482.Search in Google Scholar PubMed PubMed Central
22. Zeng, X, Xing, H, Wei, Y, Tang, Z, Lu, X, Wang, Z, et al.. Monocyte volumetric parameters and lymph index are increased in SARS-CoV-2 infection. Int J Lab Hematol 2020;42:e266–9. https://doi.org/10.1111/ijlh.13323.Search in Google Scholar PubMed PubMed Central
23. Marcos-Morales, A, Barea-Mendoza, JA, Garcia-Fuentes, C, Cueto-Felgueroso, C, Lopez-Jimenez, A, Martin-Loeches, I, et al.. Elevated monocyte distribution width in trauma: an early cellular biomarker of organ dysfunction. Injury 2022;53:959–65. https://doi.org/10.1016/j.injury.2021.11.026.Search in Google Scholar PubMed
24. Agnello, L, Vidali, M, Lo Sasso, B, Giglio, RV, Gambino, CM, Scazzone, C, et al.. Monocyte distribution width (MDW) as a screening tool for early detecting sepsis: a systematic review and meta-analysis. Clin Chem Lab Med 2022;60:786–92. https://doi.org/10.1515/cclm-2021-1331.Search in Google Scholar PubMed
25. Radzyukevich, YV, Kosyakova, NI, Prokhorenko, IR. Participation of monocyte subpopulations in progression of experimental endotoxemia (EE) and systemic inflammation. J Immunol Res 2021;2021:1762584. https://doi.org/10.1155/2021/1762584.Search in Google Scholar PubMed PubMed Central
26. Poz, D, Crobu, D, Sukhacheva, E, Rocchi, MBL, Anelli, MC, Curcio, F. Monocyte distribution width (MDW): a useful biomarker to improve sepsis management in emergency department. Clin Chem Lab Med 2022;60:433–40. https://doi.org/10.1515/cclm-2021-0875.Search in Google Scholar PubMed
27. Piva, E, Zuin, J, Pelloso, M, Tosato, F, Fogar, P, Plebani, M. Monocyte distribution width (MDW) parameter as a sepsis indicator in intensive care units. Clin Chem Lab Med 2021;59:1307–14. https://doi.org/10.1515/cclm-2021-0192.Search in Google Scholar PubMed
28. Agnello, L, Giglio, RV, Bivona, G, Scazzone, C, Gambino, CM, Iacona, A, et al.. The value of a complete blood count (CBC) for sepsis diagnosis and prognosis. Diagnostics 2021;11. https://doi.org/10.3390/diagnostics11101881.Search in Google Scholar PubMed PubMed Central
29. Agnello, L, Lo Sasso, B, Vidali, M, Scazzone, C, Gambino, CM, Giglio, RV, et al.. Validation of monocyte distribution width decisional cutoff for sepsis detection in the acute setting. Int J Lab Hematol 2021;43:O183–5. https://doi.org/10.1111/ijlh.13496.Search in Google Scholar PubMed
30. Agnello, L, Iacona, A, Lo Sasso, B, Scazzone, C, Pantuso, M, Giglio, RV, et al.. A new tool for sepsis screening in the emergency department. Clin Chem Lab Med 2021;59:1600–5. https://doi.org/10.1515/cclm-2021-0208.Search in Google Scholar PubMed
31. Polilli, E, Frattari, A, Esposito, JE, Stanziale, A, Giurdanella, G, Di Iorio, G, et al.. Monocyte distribution width (MDW) as a new tool for the prediction of sepsis in critically ill patients: a preliminary investigation in an intensive care unit. BMC Emerg Med 2021;21:147. https://doi.org/10.1186/s12873-021-00521-4.Search in Google Scholar PubMed PubMed Central
32. Polilli, E, Frattari, A, Esposito, JE, D’Amato, M, Rapacchiale, G, D’Intino, A, et al.. Reliability of predictive models to support early decision making in the emergency department for patients with confirmed diagnosis of COVID-19: the Pescara Covid Hospital score. BMC Health Serv Res 2022;22:1062. https://doi.org/10.1186/s12913-022-08421-4.Search in Google Scholar PubMed PubMed Central
33. Crouser, ED, Parrillo, JE, Seymour, CW, Angus, DC, Bicking, K, Esguerra, VG, et al.. Monocyte distribution width: a novel indicator of sepsis-2 and sepsis-3 in high-risk emergency department patients. Crit Care Med 2019;47:1018–25. https://doi.org/10.1097/ccm.0000000000003799.Search in Google Scholar
34. Polilli, E, Sozio, F, Frattari, A, Persichitti, L, Sensi, M, Posata, R, et al.. Comparison of monocyte distribution width (MDW) and procalcitonin for early recognition of sepsis. PLoS One 2020;15:e0227300. https://doi.org/10.1371/journal.pone.0227300.Search in Google Scholar PubMed PubMed Central
35. Wan, X, Wang, W, Liu, J, Tong, T. Estimating the sample mean and standard deviation from the sample size, median, range and/or interquartile range. BMC Med Res Methodol 2014;14:135. https://doi.org/10.1186/1471-2288-14-135.Search in Google Scholar PubMed PubMed Central
36. Stratan, L, Tiliscan, C, Arama, V, Lazar, M, Visan, A, Ganea, O, et al.. COVID-19 associated coagulopathy is correlated with increased age and markers of inflammation response. Rev Rom Med Lab 2021;29:387–94. https://doi.org/10.2478/rrlm-2021-0031.Search in Google Scholar
37. Kim, SW, Lee, H, Lee, SH, Jo, SJ, Lee, J, Lim, J. Usefulness of monocyte distribution width and presepsin for early assessment of disease severity in COVID-19 patients. Medicine 2022;101:e29592. https://doi.org/10.1097/md.0000000000029592.Search in Google Scholar PubMed PubMed Central
38. Cusinato, M, Hadcocks, L, Yona, S, Planche, T, Macallan, D. Increased monocyte distribution width in COVID-19 and sepsis arises from a complex interplay of altered monocyte cellular size and subset frequency. Int J Lab Hematol 2022;44:1029–39. https://doi.org/10.1111/ijlh.13941.Search in Google Scholar PubMed PubMed Central
39. Luke, F, Orso, E, Kirsten, J, Poeck, H, Grube, M, Wolff, D, et al.. Coronavirus disease 2019 induces multi-lineage, morphologic changes in peripheral blood cells. EJH 2020;1:376–83. https://doi.org/10.1002/jha2.44.Search in Google Scholar PubMed PubMed Central
40. Pozdnyakova, O, Connell, NT, Battinelli, EM, Connors, JM, Fell, G, Kim, AS. Clinical significance of CBC and WBC morphology in the diagnosis and clinical course of COVID-19 infection. Am J Clin Pathol 2021;155:364–75. https://doi.org/10.1093/ajcp/aqaa231.Search in Google Scholar PubMed PubMed Central
41. Jain, S, Meena, R, Kumar, V, Kaur, R, Tiwari, U. Comparison of hematologic abnormalities between hospitalized coronavirus disease 2019 positive and negative patients with correlation to disease severity and outcome. J Med Virol 2022;94:3757–67. https://doi.org/10.1002/jmv.27793.Search in Google Scholar PubMed PubMed Central
42. Zhang, D, Guo, R, Lei, L, Liu, H, Wang, Y, Wang, Y, et al.. Frontline Science: COVID-19 infection induces readily detectable morphologic and inflammation-related phenotypic changes in peripheral blood monocytes. J Leukoc Biol 2021;109:13–22. https://doi.org/10.1002/jlb.4hi0720-470r.Search in Google Scholar
43. Gustine, JN, Jones, D. Immunopathology of hyperinflammation in COVID-19. Am J Pathol 2021;191:4–17. https://doi.org/10.1016/j.ajpath.2020.08.009.Search in Google Scholar PubMed PubMed Central
44. Nazarullah, A, Liang, C, Villarreal, A, Higgins, RA, Mais, DD. Peripheral blood examination findings in SARS-CoV-2 infection. Am J Clin Pathol 2020;154:319–29. https://doi.org/10.1093/ajcp/aqaa108.Search in Google Scholar PubMed PubMed Central
45. Ligi, D, Maniscalco, R, Plebani, M, Lippi, G, Mannello, F. Do circulating histones represent the missing link among COVID-19 infection and multiorgan injuries, microvascular coagulopathy and systemic hyperinflammation? J Clin Med 2022;11:1800. https://doi.org/10.3390/jcm11071800.Search in Google Scholar PubMed PubMed Central
46. Shaw, RJ, Abrams, ST, Austin, J, Taylor, JM, Lane, S, Dutt, T, et al.. Circulating histones play a central role in COVID-19-associated coagulopathy and mortality. Haematologica 2021;106:2493–8. https://doi.org/10.3324/haematol.2021.278492.Search in Google Scholar PubMed PubMed Central
47. Ligi, D, Lo Sasso, B, Giglio, RV, Maniscalco, R, DellaFranca, C, Agnello, L, et al.. Circulating histones contribute to monocyte and MDW alterations as common mediators in classical and COVID-19 sepsis. Crit Care 2022;26:260. https://doi.org/10.1186/s13054-022-04138-2.Search in Google Scholar PubMed PubMed Central
48. Henry, BM, de Oliveira, MHS, Benoit, S, Plebani, M, Lippi, G. Hematologic, biochemical and immune biomarker abnormalities associated with severe illness and mortality in coronavirus disease 2019 (COVID-19): a meta-analysis. Clin Chem Lab Med 2020;58:1021–8. https://doi.org/10.1515/cclm-2020-0369.Search in Google Scholar PubMed
49. Bikdeli, B, Madhavan, MV, Gupta, A, Jimenez, D, Burton, JR, Der Nigoghossian, C, et al.. Pharmacological agents targeting thromboinflammation in COVID-19: review and implications for future research. Thromb Haemostasis 2020;120:1004–24. https://doi.org/10.1055/s-0040-1713152.Search in Google Scholar PubMed PubMed Central
50. Pourbagheri-Sigaroodi, A, Bashash, D, Fateh, F, Abolghasemi, H. Laboratory findings in COVID-19 diagnosis and prognosis. Clin Chim Acta 2020;510:475–82. https://doi.org/10.1016/j.cca.2020.08.019.Search in Google Scholar PubMed PubMed Central
51. Christensen, B, Favaloro, EJ, Lippi, G, Van Cott, EM. Hematology laboratory abnormalities in patients with coronavirus disease 2019 (COVID-19). Semin Thromb Hemost 2020;46:845–9. https://doi.org/10.1055/s-0040-1715458.Search in Google Scholar PubMed PubMed Central
52. Ackermann, M, Anders, HJ, Bilyy, R, Bowlin, GL, Daniel, C, De Lorenzo, R, et al.. Patients with COVID-19: in the dark-NETs of neutrophils. Cell Death Differ 2021;28:3125–39. https://doi.org/10.1038/s41418-021-00805-z.Search in Google Scholar PubMed PubMed Central
53. Ondracek, AS, Lang, IM. Neutrophil extracellular traps as prognostic markers in COVID-19: a welcome piece to the puzzle. Arterioscler Thromb Vasc Biol 2021;41:995–8. https://doi.org/10.1161/atvbaha.120.315633.Search in Google Scholar PubMed PubMed Central
54. Barnes, BJ, Adrover, JM, Baxter-Stoltzfus, A, Borczuk, A, Cools-Lartigue, J, Crawford, JM, et al.. Targeting potential drivers of COVID-19: neutrophil extracellular traps. J Exp Med 2020;217:e20200652.10.1084/jem.20200652Search in Google Scholar PubMed PubMed Central
55. Fei, Y, Tang, N, Liu, H, Cao, W. Coagulation dysfunction. Arch Pathol Lab Med 2020;144:1223–9. https://doi.org/10.5858/arpa.2020-0324-sa.Search in Google Scholar PubMed
56. Hernandez-Huerta, MT, Perez-Santiago, AD, Perez-Campos Mayoral, L, Sanchez Navarro, LM, Rodal Canales, FJ, Majluf-Cruz, A, et al.. Mechanisms of immunothrombosis by SARS-CoV-2. Biomolecules 2021;11:1550. https://doi.org/10.3390/biom11111550.Search in Google Scholar PubMed PubMed Central
57. Zuo, Y, Zuo, M, Yalavarthi, S, Gockman, K, Madison, JA, Shi, H, et al.. Neutrophil extracellular traps and thrombosis in COVID-19. J Thromb Thrombolysis 2021;51:446–53. https://doi.org/10.1007/s11239-020-02324-z.Search in Google Scholar PubMed PubMed Central
58. Ligi, D, Giglio, RV, Henry, BM, Lippi, G, Ciaccio, M, Plebani, M, et al.. What is the impact of circulating histones in COVID-19: a systematic review. Clin Chem Lab Med 2022;60:1506–17. https://doi.org/10.1515/cclm-2022-0574.Search in Google Scholar PubMed
59. Silk, E, Zhao, H, Weng, H, Ma, D. The role of extracellular histone in organ injury. Cell Death Dis 2017;8:e2812. https://doi.org/10.1038/cddis.2017.52.Search in Google Scholar PubMed PubMed Central
60. Singh, A, Verma, S, Modak, SB, Chaturvedi, MM, Purohit, JS. Extra-nuclear histones: origin, significance and perspectives. Mol Cell Biochem 2022;477:507–24. https://doi.org/10.1007/s11010-021-04300-4.Search in Google Scholar PubMed
61. Veras, FP, Pontelli, MC, Silva, CM, Toller-Kawahisa, JE, de Lima, M, Nascimento, DC, et al.. SARS-CoV-2-triggered neutrophil extracellular traps mediate COVID-19 pathology. J Exp Med 2020;217:e20201129. https://doi.org/10.1084/jem.20201129.Search in Google Scholar PubMed PubMed Central
62. Hong, W, Yang, J, Zou, J, Bi, Z, He, C, Lei, H, et al.. Histones released by NETosis enhance the infectivity of SARS-CoV-2 by bridging the spike protein subunit 2 and sialic acid on host cells. Cell Mol Immunol 2022;19:577–87. https://doi.org/10.1038/s41423-022-00845-6.Search in Google Scholar PubMed PubMed Central
63. Ng, H, Havervall, S, Rosell, A, Aguilera, K, Parv, K, von Meijenfeldt, FA, et al.. Circulating markers of neutrophil extracellular traps are of prognostic value in patients with COVID-19. Arterioscler Thromb Vasc Biol 2021;41:988–94. https://doi.org/10.1161/atvbaha.120.315267.Search in Google Scholar
64. Hu, B, Guo, H, Zhou, P, Shi, ZL. Characteristics of SARS-CoV-2 and COVID-19. Nat Rev Microbiol 2021;19:141–54. https://doi.org/10.1038/s41579-020-00459-7.Search in Google Scholar PubMed PubMed Central
65. Meidaninikjeh, S, Sabouni, N, Marzouni, HZ, Bengar, S, Khalili, A, Jafari, R. Monocytes and macrophages in COVID-19: friends and foes. Life Sci 2021;269:119010. https://doi.org/10.1016/j.lfs.2020.119010.Search in Google Scholar PubMed PubMed Central
66. Gando, S, Wada, T. Thromboplasminflammation in COVID-19 coagulopathy: three viewpoints for diagnostic and therapeutic strategies. Front Immunol 2021;12:649122. https://doi.org/10.3389/fimmu.2021.649122.Search in Google Scholar PubMed PubMed Central
67. Hottz, ED, Martins-Gonçalves, R, Palhinha, L, Azevedo-Quintanilha, IG, de Campos, MM, Sacramento, CQ, et al.. Platelet-monocyte interaction amplifies thromboinflammation through tissue factor signaling in COVID-19. Blood Adv 2022;6:5085–99. https://doi.org/10.1182/bloodadvances.2021006680.Search in Google Scholar PubMed PubMed Central
68. Li, T, Yang, Y, Li, Y, Wang, Z, Ma, F, Luo, R, et al.. Platelets mediate inflammatory monocyte activation by SARS-CoV-2 spike protein. J Clin Invest 2022;132:e150101. https://doi.org/10.1172/jci150101.Search in Google Scholar PubMed PubMed Central
69. Hou, SK, Lin, HA, Tsai, HW, Lin, CF, Lin, SF. Monocyte distribution width in children with systemic inflammatory response: retrospective cohort examining association with early sepsis. Pediatr Crit Care Med 2022;23:698–707. https://doi.org/10.1097/pcc.0000000000003019.Search in Google Scholar PubMed
70. Yonker, LM, Badaki-Makun, O, Arya, P, Boribong, BP, Moraru, G, Fenner, B, et al.. Monocyte anisocytosis increases during multisystem inflammatory syndrome in children with cardiovascular complications. BMC Infect Dis 2022;22:563. https://doi.org/10.1186/s12879-022-07526-9.Search in Google Scholar PubMed PubMed Central
71. Radia, T, Williams, N, Agrawal, P, Harman, K, Weale, J, Cook, J, et al.. Multi-system inflammatory syndrome in children & adolescents (MIS-C): a systematic review of clinical features and presentation. Paediatr Respir Rev 2021;38:51–7. https://doi.org/10.1016/j.prrv.2020.08.001.Search in Google Scholar PubMed PubMed Central
72. Feldstein, LR, Tenforde, MW, Friedman, KG, Newhams, M, Rose, EB, Dapul, H, et al.. Characteristics and outcomes of US children and adolescents with multisystem inflammatory syndrome in children (MIS-C) compared with severe acute COVID-19. JAMA 2021;325:1074–87. https://doi.org/10.1001/jama.2021.2091.Search in Google Scholar PubMed PubMed Central
73. Higgins, TL, Stark, MM, Henson, KN, Freeseman-Freeman, L. Coronavirus disease 2019 ICU patients have higher-than-expected acute physiology and chronic health evaluation-adjusted mortality and Length of Stay than viral pneumonia ICU patients. Crit Care Med 2021;49:e701–6. https://doi.org/10.1097/ccm.0000000000005012.Search in Google Scholar
74. Higgins, V, Sohaei, D, Diamandis, EP, Prassas, I. COVID-19: from an acute to chronic disease? Potential long-term health consequences. Crit Rev Clin Lab Sci 2021;58:297–310. https://doi.org/10.1080/10408363.2020.1860895.Search in Google Scholar PubMed
75. Yong, SJ. Long COVID or post-COVID-19 syndrome: putative pathophysiology, risk factors, and treatments. Infect Dis 2021;53:737–54. https://doi.org/10.1080/23744235.2021.1924397.Search in Google Scholar PubMed PubMed Central
76. Desai, AD, Lavelle, M, Boursiquot, BC, Wan, EY. Long-term complications of COVID-19. Am J Physiol Cell Physiol 2022;322:C1–11. https://doi.org/10.1152/ajpcell.00375.2021.Search in Google Scholar PubMed PubMed Central
77. Chen, CH, Lin, SW, Shen, CF, Hsieh, KS, Cheng, CM. Biomarkers during COVID-19: mechanisms of change and implications for patient outcomes. Diagnostics 2022;12:509. https://doi.org/10.3390/diagnostics12020509.Search in Google Scholar PubMed PubMed Central
78. Lippi, G, Sanchis-Gomar, F, Henry, BM. Coronavirus disease 2019 (COVID-19): the portrait of a perfect storm. Ann Transl Med 2020;8:497. https://doi.org/10.21037/atm.2020.03.157.Search in Google Scholar PubMed PubMed Central
79. Lippi, G, Henry, BM, Favaloro, EJ. The benefits of heparin use in COVID-19: pleiotropic antiviral activity beyond anticoagulant and anti-inflammatory properties. Semin Thromb Hemost 2022. https://doi.org/10.1055/s-0042-1742740. in press.Search in Google Scholar PubMed
80. Shi, H, Gandhi, AA, Smith, SA, Wang, Q, Chiang, D, Yalavarthi, S, et al.. Endothelium-protective, histone-neutralizing properties of the polyanionic agent defibrotide. JCI Insight 2021;6:e149149. https://doi.org/10.1172/jci.insight.149149.Search in Google Scholar PubMed PubMed Central
81. Sharma, N, Haggstrom, L, Sohrabipour, S, Dwivedi, DJ, Liaw, PC. Investigations of the effectiveness of heparin variants as inhibitors of histones. J Thromb Haemostasis 2022;20:1485–95. https://doi.org/10.1111/jth.15706.Search in Google Scholar PubMed
82. Pence, BD. Atypical monocytes in COVID-19: lighting the fire of cytokine storm? J Leukoc Biol 2021;109:7–8. https://doi.org/10.1002/jlb.5ce0920-613r.Search in Google Scholar
83. Seery, V, Raiden, SC, Algieri, SC, Grisolia, NA, Filippo, D, De Carli, N, et al.. Blood neutrophils from children with COVID-19 exhibit both inflammatory and anti-inflammatory markers. EBioMedicine 2021;67:103357. https://doi.org/10.1016/j.ebiom.2021.103357.Search in Google Scholar PubMed PubMed Central
84. Lipp, P, Ruhnau, J, Lange, A, Vogelgesang, A, Dressel, A, Heckmann, M. Less neutrophil extracellular trap formation in term newborns than in adults. Neonatology 2017;111:182–8. https://doi.org/10.1159/000452615.Search in Google Scholar PubMed
85. Pence, BD. Aging and monocyte immunometabolism in COVID-19. Aging 2021;13:9154–5. https://doi.org/10.18632/aging.202918.Search in Google Scholar PubMed PubMed Central
86. Pence, BD. Severe COVID-19 and aging: are monocytes the key? GeroScience 2020;42:1051–61. https://doi.org/10.1007/s11357-020-00213-0.Search in Google Scholar PubMed PubMed Central
87. Aymonnier, K, Ng, J, Fredenburgh, LE, Zambrano-Vera, K, Munzer, P, Gutch, S, et al.. Inflammasome activation in neutrophils of patients with severe COVID-19. Blood Adv 2022;6:2001–13. https://doi.org/10.1182/bloodadvances.2021005949.Search in Google Scholar PubMed PubMed Central
88. Zhang, X, Li, X. The role of histones and heparin in sepsis: a review. J Intensive Care Med 2022;37:319–26. https://doi.org/10.1177/0885066621992320.Search in Google Scholar PubMed
© 2022 Walter de Gruyter GmbH, Berlin/Boston
Articles in the same Issue
- Frontmatter
- Editorial
- Improving access to diagnostic testing in conflict-affected areas: what is needed?
- Review
- Deciphering the role of monocyte and monocyte distribution width (MDW) in COVID-19: an updated systematic review and meta-analysis
- Opinion Paper
- From research cohorts to the patient – a role for “omics” in diagnostics and laboratory medicine?
- EFLM Paper
- The European Register of Specialists in Clinical Chemistry and Laboratory Medicine: code of conduct, version 3 – 2023
- Guidelines and Recommendations
- Cardiac troponin measurement at the point of care: educational recommendations on analytical and clinical aspects by the IFCC Committee on Clinical Applications of Cardiac Bio-Markers (IFCC C-CB)
- Genetics and Molecular Diagnostics
- A new and improved method of library preparation for non-invasive prenatal testing: plasma to library express technology
- Multiplex proteomics using proximity extension assay for the identification of protein biomarkers predictive of acute graft-vs.-host disease in allogeneic hematopoietic cell transplantation
- General Clinical Chemistry and Laboratory Medicine
- Assessment of laboratory capacity in conflict-affected low-resource settings using two World Health Organization laboratory assessment tools
- Challenge in hyponatremic patients – the potential of a laboratory-based decision support system for hyponatremia to improve patient’s safety
- Evaluation of hemolysis, lipemia, and icterus interference with common clinical immunoassays
- Serum bicarbonate stability study at room temperature – influence of time to centrifugation and air exposure on bicarbonate measurement reported according to the CRESS checklist
- Effects of lipemia on capillary serum protein electrophoresis in native ultra-lipemic material and intravenous lipid emulsion added sera
- C-reactive protein interacts with amphotericin B liposomes and its potential clinical consequences
- Evaluation of analytical performance of homocysteine LC-MS/MS assay and design of internal quality control strategy
- A reliable and high throughput HPLC–HRMS method for the rapid screening of β-thalassemia and hemoglobinopathy in dried blood spots
- Dynamics of the vitamin D C3-epimer levels in preterm infants
- Comparison of ANA testing by indirect immunofluorescence or solid-phase assays in a low pre-test probability population for systemic autoimmune disease: the Camargo Cohort
- Reference Values and Biological Variations
- LMS-based continuous reference percentiles for 14 laboratory parameters in the CALIPER cohort of healthy children and adolescents
- Indirectly determined reference intervals for automated white blood cell differentials of pediatric patients in Berlin and Brandenburg
- Infectious Diseases
- Evaluation of a high-sensitivity SARS-CoV-2 antigen test on the fully automated light-initiated chemiluminescent immunoassay platform
- Letters to the Editor
- Non-esterified fatty acids (NEFA): sample stability and effect of haemolysis and icterus
- Frozen serum sample pool should not be used as internal quality assessment for lipemia (L) index
- Stability of SARS-CoV-2 respiratory samples in non-freezing condition: importance for tropical countries under heavy diagnostic demand
- A rare case of both macro-TSH and macro-LH: laboratory analysis of the pathogenesis
- A new method for early cancer detection based on platelet transcriptomics will have low positive predictive value
- Comparison of near-infrared and UV–vis-based non-contact hematocrit prediction of dried blood spots from patients on immunosuppressants
- The diagnostics of heparin-induced thrombocytopenia in Italy and the possible impact of vaccine-induced immune thrombotic thrombocytopenia on it
- Pitfall in the analysis of the alcohol biomarkers ethyl glucuronide and ethyl sulfate by laboratory-caused contamination with disinfectants
- Growing your own food is like printing money, don’t let it make you mad as a hatter
- Congress Abstracts
- 43rd annual conference of the association of clinical biochemists in Ireland (ACBI 2021)
- 44th Annual Conference of the Association of Clinical Biochemists in Ireland (ACBI 2022)
Articles in the same Issue
- Frontmatter
- Editorial
- Improving access to diagnostic testing in conflict-affected areas: what is needed?
- Review
- Deciphering the role of monocyte and monocyte distribution width (MDW) in COVID-19: an updated systematic review and meta-analysis
- Opinion Paper
- From research cohorts to the patient – a role for “omics” in diagnostics and laboratory medicine?
- EFLM Paper
- The European Register of Specialists in Clinical Chemistry and Laboratory Medicine: code of conduct, version 3 – 2023
- Guidelines and Recommendations
- Cardiac troponin measurement at the point of care: educational recommendations on analytical and clinical aspects by the IFCC Committee on Clinical Applications of Cardiac Bio-Markers (IFCC C-CB)
- Genetics and Molecular Diagnostics
- A new and improved method of library preparation for non-invasive prenatal testing: plasma to library express technology
- Multiplex proteomics using proximity extension assay for the identification of protein biomarkers predictive of acute graft-vs.-host disease in allogeneic hematopoietic cell transplantation
- General Clinical Chemistry and Laboratory Medicine
- Assessment of laboratory capacity in conflict-affected low-resource settings using two World Health Organization laboratory assessment tools
- Challenge in hyponatremic patients – the potential of a laboratory-based decision support system for hyponatremia to improve patient’s safety
- Evaluation of hemolysis, lipemia, and icterus interference with common clinical immunoassays
- Serum bicarbonate stability study at room temperature – influence of time to centrifugation and air exposure on bicarbonate measurement reported according to the CRESS checklist
- Effects of lipemia on capillary serum protein electrophoresis in native ultra-lipemic material and intravenous lipid emulsion added sera
- C-reactive protein interacts with amphotericin B liposomes and its potential clinical consequences
- Evaluation of analytical performance of homocysteine LC-MS/MS assay and design of internal quality control strategy
- A reliable and high throughput HPLC–HRMS method for the rapid screening of β-thalassemia and hemoglobinopathy in dried blood spots
- Dynamics of the vitamin D C3-epimer levels in preterm infants
- Comparison of ANA testing by indirect immunofluorescence or solid-phase assays in a low pre-test probability population for systemic autoimmune disease: the Camargo Cohort
- Reference Values and Biological Variations
- LMS-based continuous reference percentiles for 14 laboratory parameters in the CALIPER cohort of healthy children and adolescents
- Indirectly determined reference intervals for automated white blood cell differentials of pediatric patients in Berlin and Brandenburg
- Infectious Diseases
- Evaluation of a high-sensitivity SARS-CoV-2 antigen test on the fully automated light-initiated chemiluminescent immunoassay platform
- Letters to the Editor
- Non-esterified fatty acids (NEFA): sample stability and effect of haemolysis and icterus
- Frozen serum sample pool should not be used as internal quality assessment for lipemia (L) index
- Stability of SARS-CoV-2 respiratory samples in non-freezing condition: importance for tropical countries under heavy diagnostic demand
- A rare case of both macro-TSH and macro-LH: laboratory analysis of the pathogenesis
- A new method for early cancer detection based on platelet transcriptomics will have low positive predictive value
- Comparison of near-infrared and UV–vis-based non-contact hematocrit prediction of dried blood spots from patients on immunosuppressants
- The diagnostics of heparin-induced thrombocytopenia in Italy and the possible impact of vaccine-induced immune thrombotic thrombocytopenia on it
- Pitfall in the analysis of the alcohol biomarkers ethyl glucuronide and ethyl sulfate by laboratory-caused contamination with disinfectants
- Growing your own food is like printing money, don’t let it make you mad as a hatter
- Congress Abstracts
- 43rd annual conference of the association of clinical biochemists in Ireland (ACBI 2021)
- 44th Annual Conference of the Association of Clinical Biochemists in Ireland (ACBI 2022)